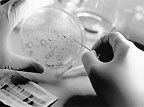

обеспечить хранение данных в течение длительного времени и при этом они более надежны, чем любой из современных носителей — как бумажных, так и электронных. Исследователи перевели текст популярной песни в код оснований ДНК, сформировали соответствующие искусственные нити ДНК, а затем внедрили их в бактерию Deinococcus radiodurans, которую считают самым жизнестойким микроорганизмом. Этот тип бактерий может переносить высокие температуры, обезвоживание, а также ультрафиолетовое и ионизирующие излучения. Кроме того, бактерии Deinococcus способны эффективно противостоять внешним мутагенным факторам. Закодированную информацию можно извлечь из ДНК потомков исходного микроорганизма спустя сотни поколений.